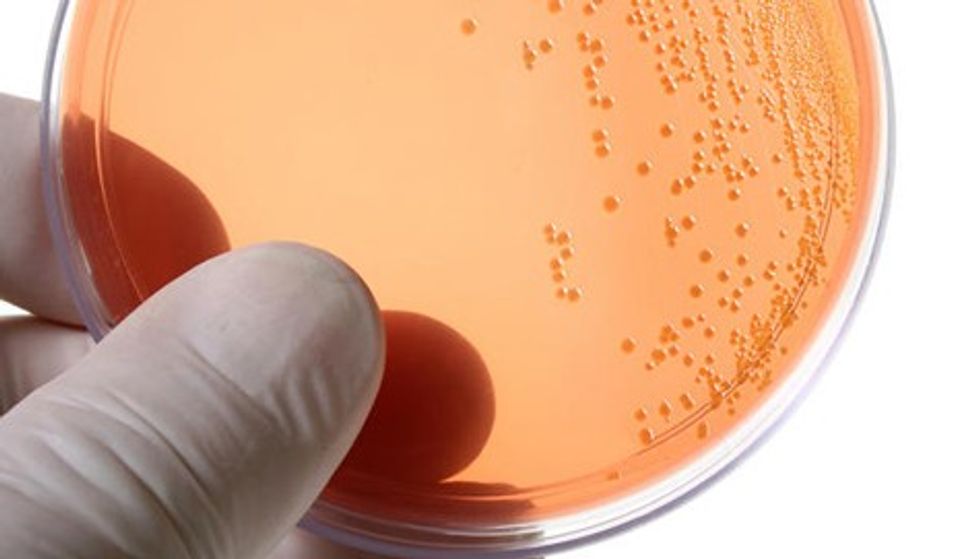
Chlamydia trachomatis culture

Infeksionet e shkaktuara me Chlamydia

Dr. Mevlyde Islami Ilijazi
gjinekologe obstetre
Chlamydia, është një shkaktare e infeksionit qe paraqitet më së shpeshti tek mosha reproduktive (te të rinjtë). Në bazë të disa të dhënave:
• Infeksioni me chlamydia është 3 herë më i shpeshtë se gonorreja dhe 5 herë më i shpeshte se sifilizi.
• Shpeshtësia e paraqitjes është mjaft e madhe. Në SHBA është raportuar se vetëm në vitin 2011 kanë qenë më se një milion e gjysmë raste të paraqitura me infeksion të chlamyidias. Mosha më e prekur ka qenë 14 -19 vjeç.
• Në gjithë botën, çdo vit zbulohen më së 90 milion raste të reja me infeksion të chlamydias.
Informimi sa më i mirë i të rinjve me pasojat e këtij infeksioni te femrat dhe meshkujt, ndihmon në parandalimin e këtyre pasojave.
Si bartet infeksioni?
* Infeksioni me chlamydia merret nga kontakti seksual me personat e infektuar
* Infeksioni mund të bartet edhe tek fëmija gjatë procesit të lindjes.
Ku atakon chlamydia të femrat?
Organet ku mund të atakoj chlamydia janë: vagjina,cerviksi, uterusi, tubat e fallopit si dhe ovariumet.
Simptomat e infeksionit
* Chlamydia mund të jetë asimptomatike në 70% të rasteve te femrat dhe 50% te rasteve te meshkujt. Zakonisht simptomat mund të paraqiten disa javë pas infektimit.
* Edhe pse nuk ka simptoma, chlamydia mund të lërë pasoja në organet reproduktive.
* Simptomat më të shpeshta që paraqiten janë: sekreti mukopurulent, djegësi gjatë urinimit, gjakderdhje jo të rregullta mes ciklit, dhimbje gjatë marrëdhënieve etj.
Periudha e inkubacionit mund të zgjasë prej 7-21 ditë.
Chlamydia mund të qëndrojë në ambiente të lagështa deri në 45 minuta.
Pasojat e mostrajtimit janë: kalimi i infeksionit në mitër dhe në tuba ku mund të shkaktojë mbylljen e tubave dhe sterilitet si dhe inflamacion të pelvikut. Mund të jetë në mënyrë të qetë, pa simptoma, por mund të shkaktojë dhimbje të barkut si dhe paraqitja e sindromës së Reiterit ku përfshihen nyjet.
Mostrajtimit të duhur pason me moszhvillim të frytit, vdekje in atero, lindje parakohe, si dhe pas lindjes, mund të vie deri te endometriti i vonshëm postpartal. Tek fëmija i porsalindur, mund të shkaktojë infeksion të syve si dhe pneumoni.
Pasojat e mostrajtimit te infeksionit te meshkujt
Tek meshkujt infeksioni me chlamydia mund të shkaktojë: Uretritis, epididimid, prostatit. Mostrajtimi i infeksionit mund të shkaktojë sterilitet.
Kush duhet të testohet për chlamydia?
• Çdo person aktiv seksual mund të infektohet me chlamydia
• Secili që ka sekret, djegësi, skuqje të pazakontë
• Për shkak se shumë njerëz të infektuar me chlamydia nuk kanë simptoma, te adultët seksual aktiv duhet të bëhet ‘screening’-u për infeksion kohë pas kohe.
Si bëhet diagnostikimi?
Diagnostikimi bëhet me marrjen e mostrës nga vagjina, cerviksi apo nga uretra si dhe testet fluoreshente; teste imunologjike të antitrupave ose me kultivim.
Trajtimi
• Trajtimi bëhet me antibiotikë: tetracycline apo aminoglikozid.
• Përcjellja e gjendjes duhet bërë në 4 javë dhe pas kësaj periudhe përsëritet testi.
• Kontrollohet a është bërë shërimi definitiv. Për shërim aplikohet terapia te të dy partnerët në mënyrë që të mos përsëritet prapë infeksioni, sikurse që njoftohen partnerët për mënyrën e bartjes së infeksionit .
• Gjithashtu, këshillohet abstenimi nga marrëdhëniet seksuale pa përdorimin e kordomave deri sa të bëhet analiza kontrolluese që tregon shërimin e pacientit. /Telegrafi/